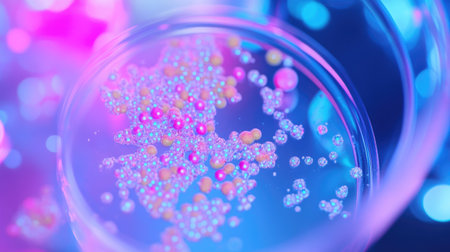
Close-up shot of bacterial culture in Petri dish, with colorful growth on agar, under bright lighting, representing life sciences.の素材

素材 - Close-up shot of bacterial culture in Petri dish, with colorful growth on agar, under bright lighting, representing life sciences.
作品情報
Close-up shot of bacterial culture in Petri dish, with colorful growth on agar, under bright lighting, representing life sciences.
- ID:258945191
- 作品種別:
- 作者名:suphauarrn Manosri
キーワード
- adult
- analysis
- background
- bacterial
- bacterium
- biochemistry
- biodiversity
- biology
- biotechnology
- blood
- chemist
- circle
- colony
- copy space
- culture
- cultures
- digital tablet
- disease
- dish
- doctor
- effort
- equipment
- experiment
- growth
- hand
- health
- health care
- healthcare and medicine
- holding
- horizontal
- human hand
- hygiene
- infection
- infectious
- innovation
- laboratory
- medicine
- microbe
- microbiology
- organism
- plate
- research
- sample
- science
- scientific
- technology
- test
- virus
類似作品
Conceptual imag...
High-res image ...
Close up view r...
Macro close up ...
Bacteria cells ...
Dynamic motion ...
Surface contami...
Bacteria and vi...
Bacteria on a s...
Threads of fung...
A close-up of b...
Enterobacterias...
Backgrounds of ...
Microbes are se...
Close-up of ger...
Colorful bacter...
Surface with ba...
A close up of a...
Blue bacteria w...
Bacteria macro ...
Diverse colorfu...
cyan colored ba...
Cells that caus...
Close-up of pat...
close-up of bac...
Close-up of mic...
Helicobacter py...
High-res image ...
Gene Mutations,...
Close-up of ger...
Visualization o...
Diverse colorfu...
Multiple bacter...
Backgrounds of ...
A detailed digi...
Microscopic bac...
Bacteria of dif...
Detailed image ...
Colorful depict...
A group of blue...
Detailed image ...
Escherichia Col...
Microscopic Vie...
Digital illustr...
High-definition...
bacterium rod m...